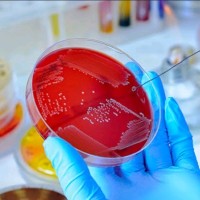
Mich Garcia

Goal oriented Individual always seeking to learn and achieve new skills.
-
 Support DeveloperDealer Spike Llc Mar 2018 - Apr 2022BelizeWorking with Web Programming languages as : HTML5, CSS3, JavaScript, jQuery, AJAX, JSON & ASP
Support DeveloperDealer Spike Llc Mar 2018 - Apr 2022BelizeWorking with Web Programming languages as : HTML5, CSS3, JavaScript, jQuery, AJAX, JSON & ASP -
High School Ict TeacherBelmopan Comprehensive School Aug 2016 - Jul 2017BelizeUpper - Level Courses
-
 Technical Support AgentBelize Telemedia Limited Oct 2015 - Aug 2016BelizeInternet, Telecommunication, Mobile , 4G , Troubleshooting
Technical Support AgentBelize Telemedia Limited Oct 2015 - Aug 2016BelizeInternet, Telecommunication, Mobile , 4G , Troubleshooting -
 Jr Web DesignerBelize Internet Marketing & Website Design Sep 2015 - Oct 2015Belmopan, Belize
Jr Web DesignerBelize Internet Marketing & Website Design Sep 2015 - Oct 2015Belmopan, Belize -
 Technical Support AgentTransparent Bpo Jun 2015 - Aug 2015Belize City, Belize C.A.Troubleshooting Customer's issues and resolving them in the Best manner
Technical Support AgentTransparent Bpo Jun 2015 - Aug 2015Belize City, Belize C.A.Troubleshooting Customer's issues and resolving them in the Best manner -
It TechnicianMinistry Of Natural Resources And Agriculture Mar 2015 - May 2015Belmopan, Belize C.A.Repairing, Troubleshooting, Network Administration and Server Mantainance
-
Administrative AssistantIlluminations Academic Solutions Jan 2014 - Jan 2015Cohune Walk, Belmopan, BelizeOnline Course Creation, Maintenance & Office Business Procedures
Michael Garcia Skills
Michael Garcia Education Details
-
 University Of BelizeInformation Technology
University Of BelizeInformation Technology
Frequently Asked Questions about Michael Garcia
What is Michael Garcia's role at the current company?
Michael Garcia's current role is 🚀 Aspiring Software Developer | Tech support pro | Customer service guru | Crafting web magic with a 😊!.
What schools did Michael Garcia attend?
Michael Garcia attended University Of Belize.
What are some of Michael Garcia's interests?
Michael Garcia has interest in Motorcycling, Jogging, Bike Riding And Innovative Technologies, Education, Environment, Science And Technology, Health.
What skills is Michael Garcia known for?
Michael Garcia has skills like Web Development, Web Design, System Administration, Repairing, Microsoft Excel, Microsoft Word, Outlook, Management, Access, Data Entry, Time Management, Software Documentation.
Not the Michael Garcia you were looking for?
-
Michael Garcia
La Grange, Il4hotmail.com, henkels.com, sea-electric.com, sea-electric.com2 +184777XXXXX
-
Mich Garcia
| Supervisory Board Member | Finance | Family Office | Philanthropy |Los Angeles Metropolitan Area -
Michael Garcia
New York, Ny5alumni.duke.edu, ubs.com, suntrustrh.com, truist.com, tdsecurities.com -
Michael Garcia
Hong Kong Sar4alumni.princeton.edu, pearson.com, wallstreetenglish.com, ge.com4 +852682XXXXX
-
Michael Garcia
Ashburn, Va5capitalone.com, bellsouth.net, netscape.net, gmail.com, capitalone.com3 +193164XXXXX
Free Chrome Extension
Find emails, phones & company data instantly
Aero Online
Your AI prospecting assistant
Select data to include:
0 records × $0.02 per record
Download 750 million emails and 100 million phone numbers
Access emails and phone numbers of over 750 million business users. Instantly download verified profiles using 20+ filters, including location, job title, company, function, and industry.
Start your free trial